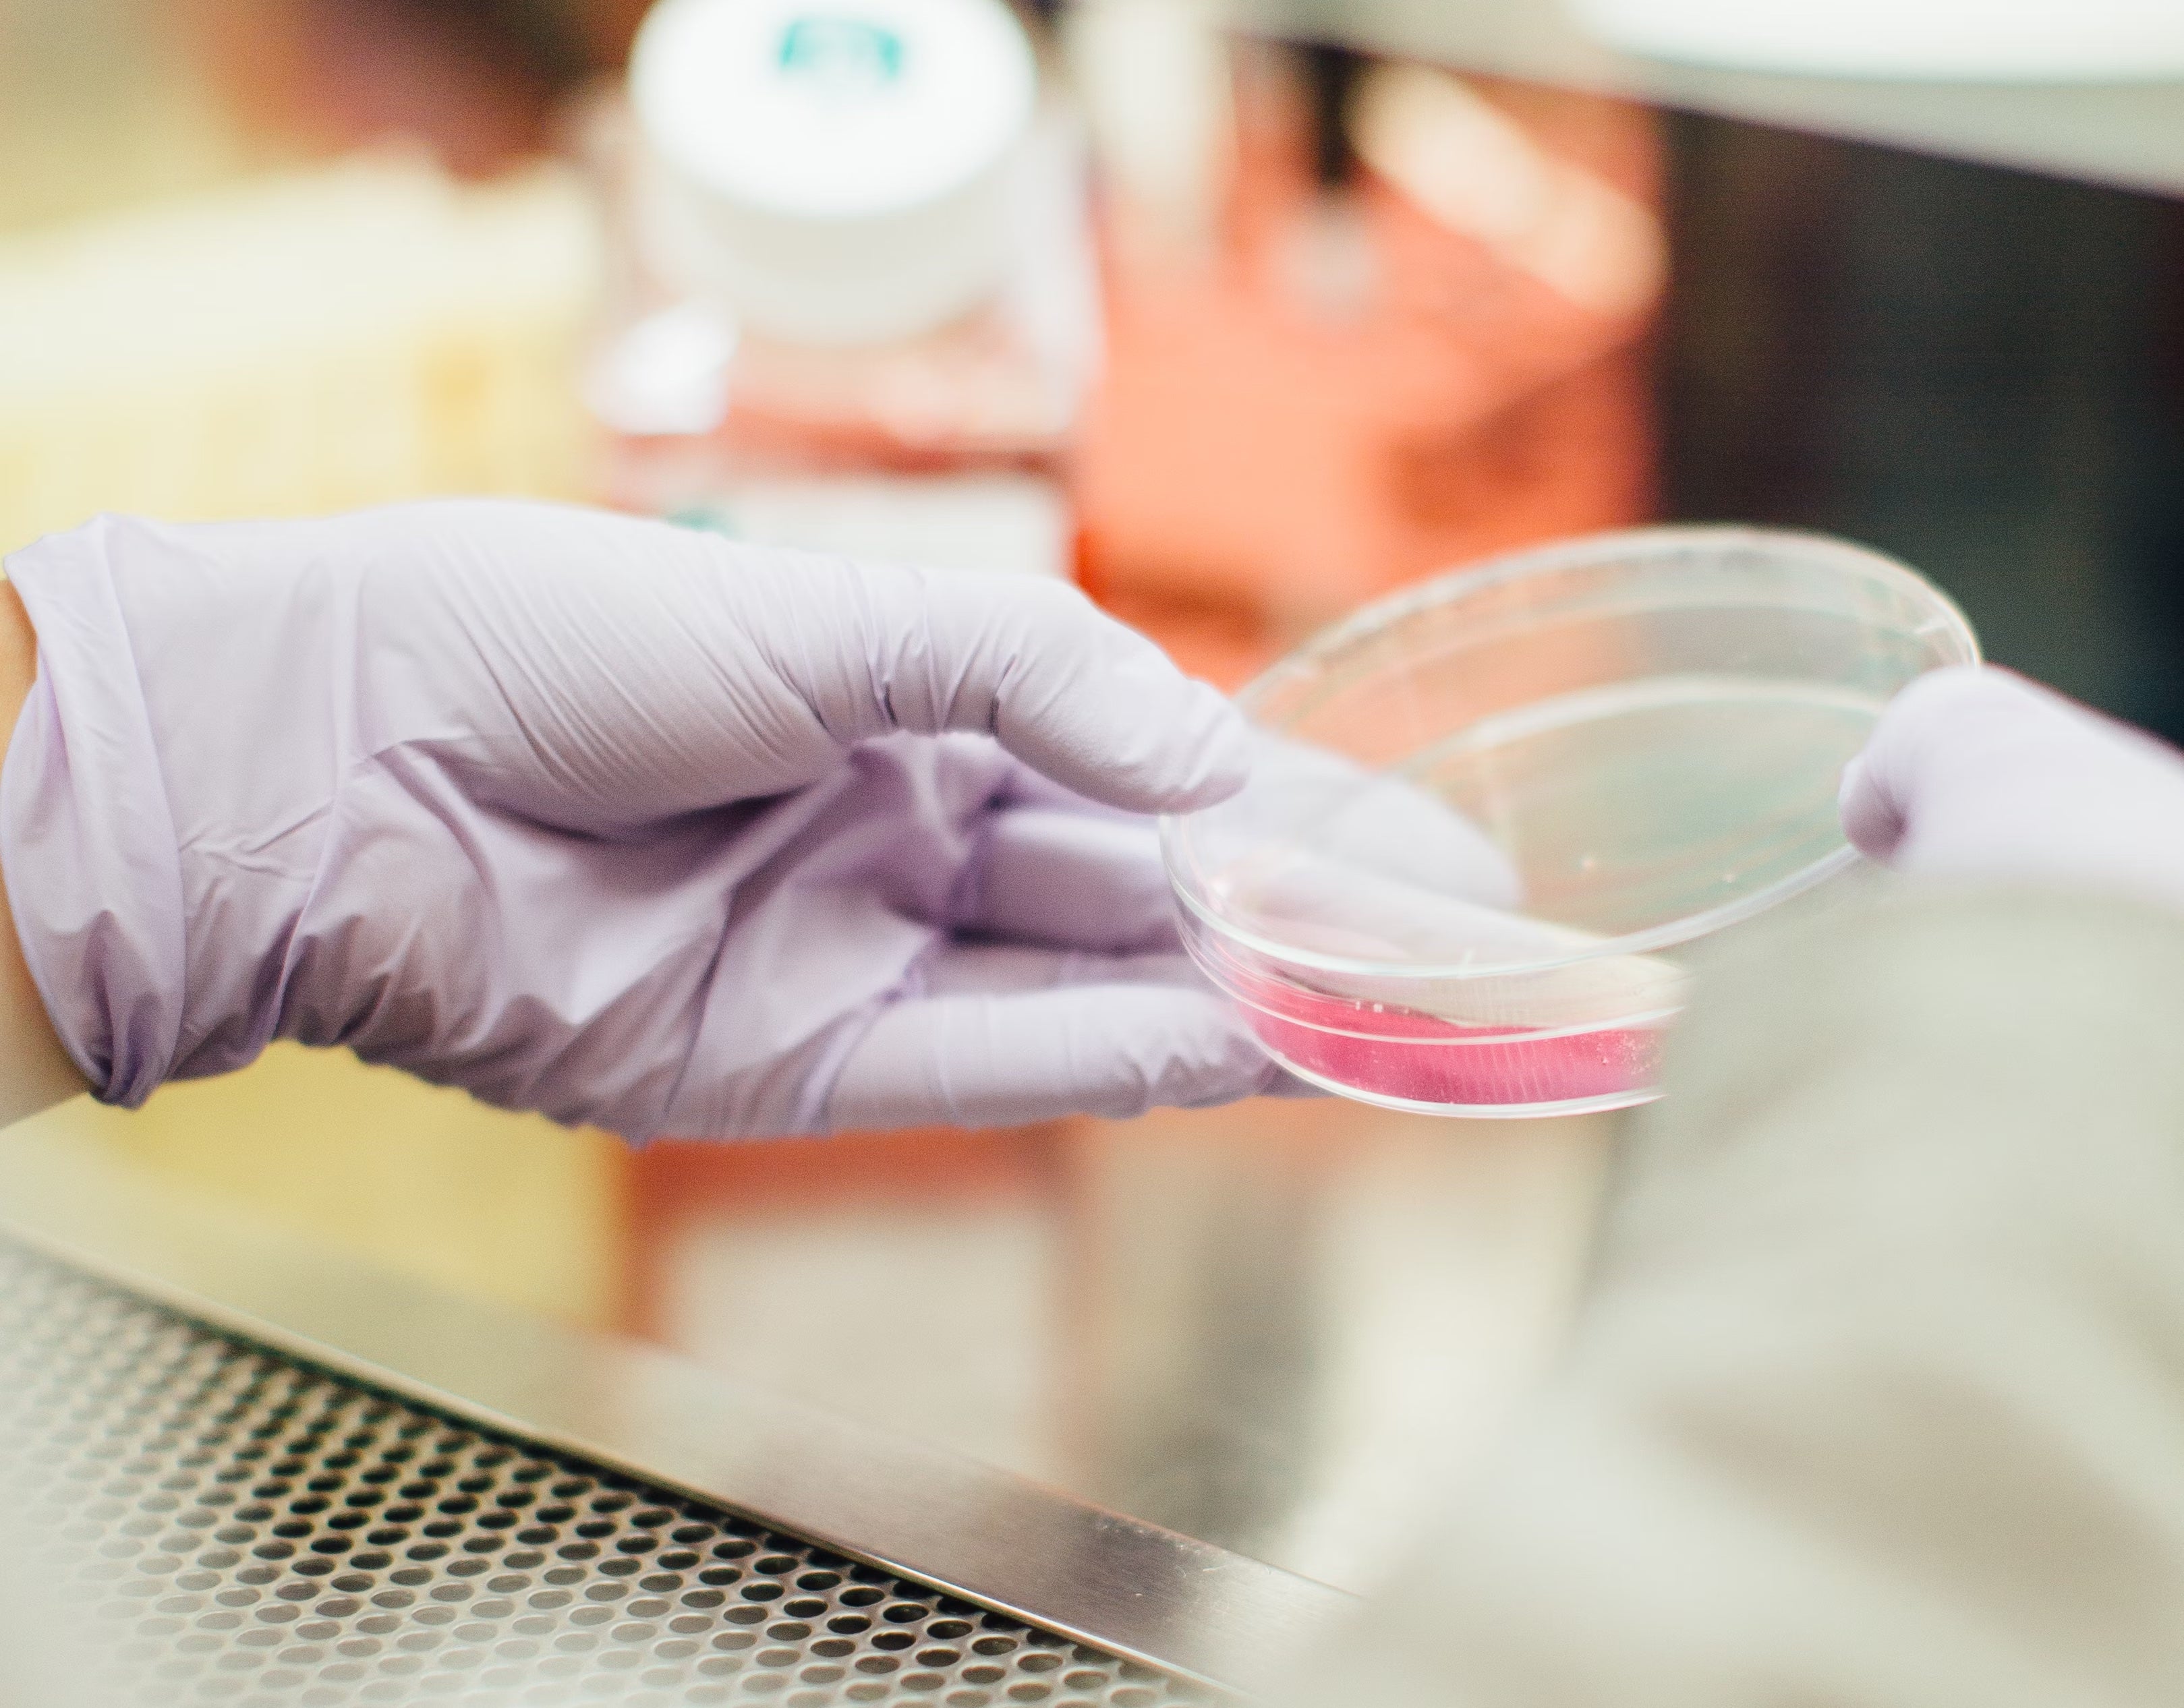

What is A Clinical Study?
Dr. Samantha Fessler holds a Master's degree in Exercise Science from East Stroudsburg University and a PhD in Exercise and Nutritional Sciences, with a focus on Physiology and Metabolism, from Arizona State University. Her research has focused on nutritional strategies targeting the interplay between inflammation and metabolism to improve health outcomes, as well as the state of perinatal nutrition and its impacts on maternal and child health outcomes. With over 8 years of experience in Exercise and Nutrition Science, Dr. Fessler is an author on several peer-reviewed publications and specializes in designing and implementing evidence-based clinical nutrition research strategies across diverse therapeutic areas.